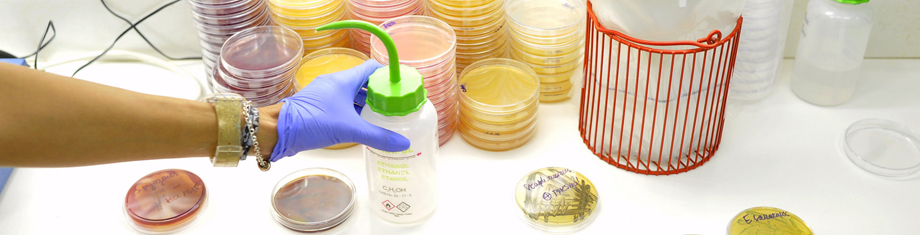

23-25 May 2016 FAO Headquarters, Rome, Italy
Recent advances in Whole Genome Sequencing (WGS) technology have the potential to play a significant role in the area food safety. WGS allows the identification and characterization of microorganisms, including antimicrobial resistance (AMR), with a level of precision not previously possible. With the rapidly declining cost of this technology, WGS applications in food safety management, including the opportunities it provides for enhanced integration of information from other sectors, such as human and animal health, could contribute to enhanced consumer protection, trade facilitation, and food/nutrition security. However, the level of understanding of the concepts and potential use of WGS for food safety management varies among countries.
Particularly for developing countries, there are capacity, regulatory and resource implications to be considered. While several industrialized countries have been moving forward with the technology, information on potential benefits, possible drawbacks, relevant challenges and considerations need to be analysed, with careful attention to developing and transitional countries with possibly limited capacity and resources. It is a role of FAO's to keep all Members informed on the latest scientific developments in the food and agriculture sectors, and provide technical assistance to those who need it.
Programme
The Technical Meeting is conducted in collaboration with the GMI (Global Microbial Identifier) initiative. Following the successful format of GMl-8, GMI-9 will replicate the format of the meeting that consists two parts:
- A one-day programme, targeting food safety managers and assessors around the world to exchange information on the impact of WGS/NGS on food safety management, for consumer protection, trade facilitation and food security.
- The two-day programme follows which includes four GMI working groups, presentations by international experts and interactive discussions. Please see the Meeting programme for more details about the meeting agenda.
Objectives and scope
The first part of the Technical Meeting provides a unique opportunity for participants in particular, those from developing/transitional countries, to understand the current applications as well as the impact of WGS on food safety management. Learning from the already existing initiatives in food and agriculture sectors, the meeting will discuss the needs, opportunities and challenges.
During the second part of the meeting (GMI9), participants benefit from the GMI initiative and actively engage in the process to develop a global system of DNA genome databases for microbial and infectious disease identification and diagnostics.
This is a Technical Meeting that will not develop policy recommendations. However, attendees from developing countries will benefit from the synthesis of current knowledge and information to better participate in international dialogues and make informed decisions.
Participants
The meeting welcomes public sector officials who are tasked to manage food safety matters, preferably those who are in the area of managing microbiological food safety risks.
FAO aims to involve experts and public-sector officials from developing countries to share their insights on opportunities and challenges in applying the WGS technology in their countries. Non-state actor experts from private sector entities (including philanthropic foundations), civil society organizations, and research/academic institutions are also welcome. Participation of officers and staff from international organizations (IGOs) is also welcome.
Venue: The meeting will start in the Red Room (A-121 INT, the 1st floor in the A building) at FAO Headquarters, Viale delle Terme di Caracalla, 00153, Rome, Italy at 8.30 hrs. The meeting room will be open from 8.00 hrs.
Programme: Download the meeting programme and visitor information.
Travel: We suggest that you arrive on Sunday, 22 May 2016 and schedule your departure from Rome after 19.00 (Rome Time) on Wednesday, 25 May 2016 or on Thursday.
Accommodation: Try to book your accommodation as soon as possible. There are hundreds of hotels in Rome. There is no corporate partnership with any hotels in connection with this Technical Meeting.
Visa: Participants requiring visas must obtain these from the Italian Consulate or competent Diplomatic Mission in their country before leaving for Rome. Visa applications must be submitted well in advance of departure, it may take up to three weeks for an Italian visa to be issued. In principle, FAO will not intervene the visa issuance process. Each participant is responsible for arranging his/her visa to enter Italy.
Registration: The deadline for registration has passed. Late registration is available for a limited number of participants. Please send us your request at [email protected]. Please note that participation of those non-state actors will be reviewed before its acceptance in order to ensure balanced representation of non-state actors in FAO meetings and processes.